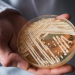
Viktima e parë në Itali nga “kërpudha vrasëse”, ja si transmetohet infeksioni

Sampdoria u konfirmua si skuadra e fundit e Serisë A për sezonin 2022/23, pavarësisht se e mbajti Sassuolo-n në një barazim 2-2 në shtëpi dhe zgjati ecurinë e tyre të pamposhtur kundër emilianëve në tre ndeshje.
Edhe pse ishte gati siguria për të përfunduar në fund të Serisë A këtë sezon, Sampdoria ishte e vendosur të luante me dinjitet dhe mori një epërsi të hershme kur Manolo Gabbiadini interceptoi pasimin e dobët të Gian Marco dhe mposhti Andrea Consiglin.
Papritur, pati 10 minuta të furishme, ku për Sassuolon, Domenico Berardi shënoi golin e tij të dhjetë në karrierë kundër Sampdoria-s, teksa barazoi 123 sekonda pas golit të vendasve.
Matheus Henrique më pas vendosi zigjelbrit, një minutë më vonë me një goditje të fortë me kokë nga krosimi i Nadir Zorteas.
Shanset ishin të shumta në të dy skajet dhe fakti që kanë pësuar dy ose më shumë gola në pesë ndeshjet e fundit jashtë fushe, epërsia e Sassuolos nuk ishte ende e sigurt.
Sulmuesi veteran i Sampdorias, Fabio Quagliarella, shkoi pranë golit me një goditje me kokë brenda zonës por, e dërgoi jashtë kuadratit.
Ndërsa po afrohej fundi i pjesës së parë me një ritëm më të qetë, Sassuolo nisi një ‘blic’, me Berardin që lëshoi një goditje të fuqishme, që ‘u stampua’ në traversë.
Momentumi u zhvendos në favor të Sassuolos dhe “Neroverdi” donin t’i jepnin fund serisë së tyre të humbjeve në katër ndeshje në transfertë, me Ceide dhe Zortea që ishin afër së vizitorëve.
Kundër çdo pritshmërie, Sampdoria befasoi Sassuolo-n me një gol kur një situatë kaotike pranë portës përfundoi me Martin Erlić që e dërgoi topin aksidentalisht në rrjetën e tij.
Sampdoria kërkoi me të gjitha forcat për të marrë një rezultat akoma më pozitiv, megjithatë ecuria e tyre pa fitore në Serie A u zgjerua në dhjetë ndeshje dhe skuadra e Dejan Stanković shkon drejt Serisë B me numrin më të ulët të pikëve të regjistruar ndonjëherë. Nga ana e saj, Sassuolo vazhdon të mbetet pa fitore në pesë takimet e fundit.

Discussion about this post